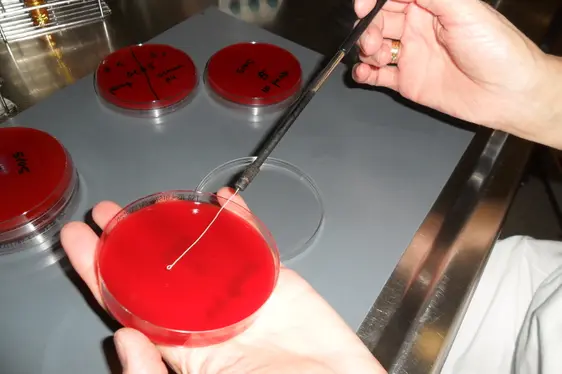
Ausstrich einer verdünnten Probe auf den Nährboden (Foto: Landesagentur für Umwelt und Klimaschutz)
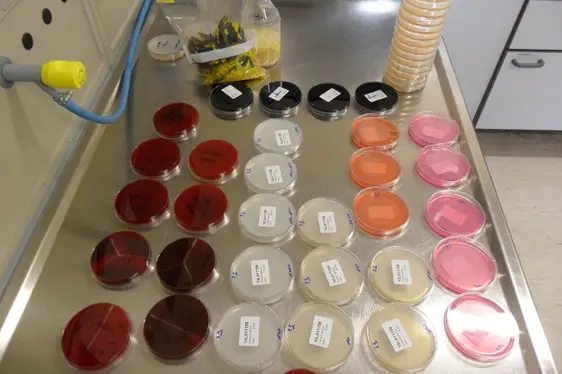
Nach erfolgter Bebrütung: selektive Nährböden mit Bakterienkulturen (Foto: Landesagentur für Umwelt und Klimaschutz)
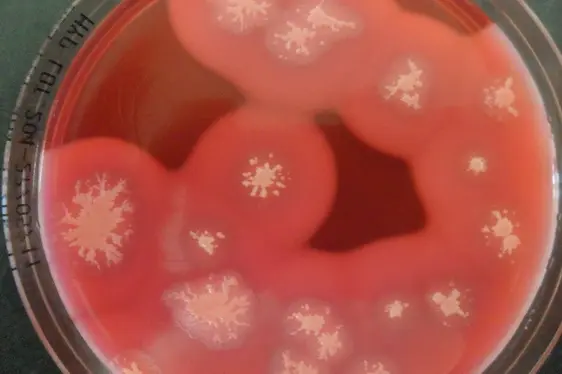
Petrischale mit Bacillus cereus-Kolonien (Foto: Landesagentur für Umwelt und Klimaschutz)
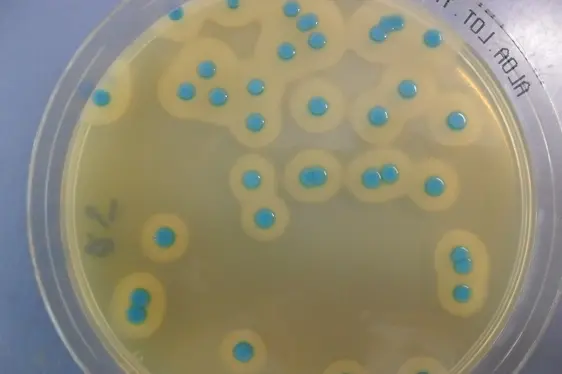
Petrischale mit Listeria monocytogenes-Kolonien (Foto: Landesagentur für Umwelt und Klimaschutz)
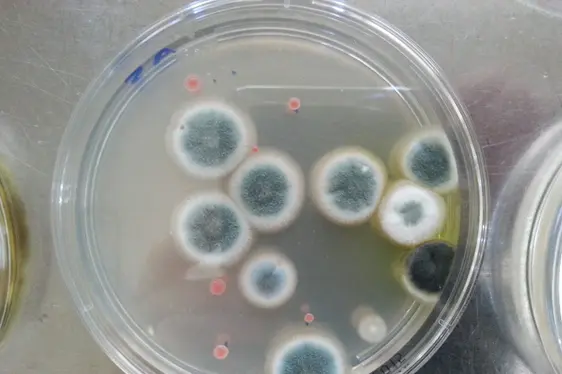
Petrischale mit Schimmelpilz-Kolonien (Foto: Landesagentur für Umwelt und Klimaschutz)

Mikrobiologische Lebensmitteluntersuchungen
Das Biologische Labor führt mikrobiologische Untersuchungen von:
- Lebensmitteln (Fertiggerichte, gastronomische Zubereitungen und ihre Ausgangsprodukte, Tiefkühlwaren, Konserven, Süßwaren, usw.)
- Umweltproben (auch Oberflächenabstriche von Lebensmittel-Kontaktflächen)
- Kosmetikprodukten durch,
und zwar sowohl für offizielle Kontrollen (welche vom Personal der Sanitätsbetriebe und der Veterinärdienste oder von der Staatspolizei (NAS) entnommen werden).
Die mikrobiologischen Untersuchungen dienen dem Nachweis und der Bestimmung von Mikroorganismen (Bakterien, Hefen und Viren) sowie der Beurteilung des Ausmaßes einer eventuellen Verunreinigung (Auszählung der gewachsenen Kolonien).
Bakterien spielen bei der Herstellung und Konservierung von Lebensmitteln eine wichtige Rolle. Einige Arten sind für die Herstellung von Lebensmitteln nützlich (zum Beispiel Bakterienkulturen bei der Käseherstellung), andere Arten weisen auf Verunreinigungen (Hygiene-Indikatoren) hin oder sind sogar eine Gefahr für die menschliche Gesundheit (pathogene Mikroorganismen).
Die am häufigsten untersuchten Parameter sind:
- Gesamtkeimzahl (mesophile Keime), mesophile Milchsäurebakterien
- Hygiene-Indikatoren und Verderbsorganismen: Coliforme Keime, Escherichia coli, Enterobakterien, fäkale Streptokokken, Hefen und Schimmelpilze
- Krankheitserregende Keime, die Lebensmittelinfektionen verursachen: zum Beispiel Salmonellen, Listerien, Bacillus cereus und deren Toxine, Clostridien, Staphylokokken und deren Toxine, Campylobakterien oder Yersinien
- Noroviren
Für die mikrobiologische Untersuchung wird eine gewisse Probenmenge auf geeignete Nährmedien in Petrischalen oder in Reagenzgläsern übertragen und bei optimalen Bedingungen für den nachzuweisenden Mikroorganismus ein bis mehrere Tage bebrütet. In dieser Zeit wachsen einzelne Mikroorganismen zu Kolonien heran und werden so mit freiem Auge sichtbar. Die anschließende Bestimmung der Art oder der Mikrobengruppe ermöglicht eine hygienisch-sanitäre Beurteilung der Probe.
Alle Untersuchungen werden nach offiziellen Methoden durchgeführt. Diese sind größtenteils vom italienischen Akkreditierungsinstitut ACCREDIA (Ente Italiano di Accreditamento) anerkannt und entsprechen der europäischen Norm UNI CEI EN ISO/IEC 17025. Auflistung der von ACCREDIA akkreditierten Untersuchungen.